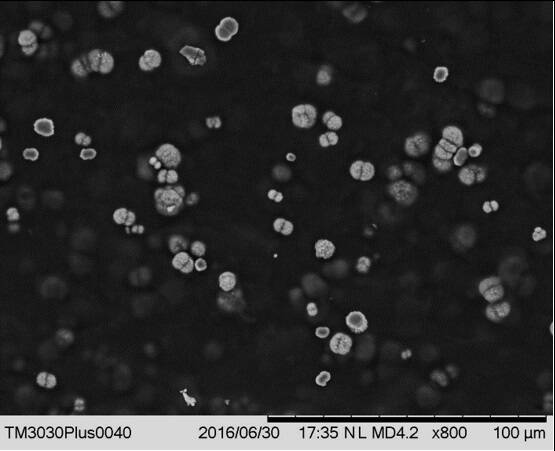

โปรตีนพืชเสมือนเนื้อสัตว์

สัมภาษณ์โดย ดร.บัญชา ธนบุญสมบัติ
ถอดบทสัมภาษณ์โดย อรวรรณ สัมฤทธิ์เดชขจร
รายการก่อ กอง Science ตอนพิเศษครั้งนี้เราคุยเรื่องอาหารอีกครั้งหนึ่ง โดยเน้นที่เนื้อสัตว์จากโปรตีนพืช ซึ่งแขกรับเชิญเป็นนักวิจัยจากทีมวัสดุศาสตร์อาหาร กลุ่มวิจัยเทคโนโลยีโพลิเมอร์ขั้นสูงของเอ็มเทค ดร.กมลวรรณ อิศราคาร หรือ ดร.ก้อย
ถาม : ดร.ก้อย จบการศึกษาด้านไหนครับ?
ตอบ:
ก้อยจบปริญญาตรี สาขาวิชาวิทยาศาสตร์การอาหารและโภชนาการ คณะวิทยาศาสตร์ แต่ปัจจุบันจะขึ้นอยู่กับคณะเทคโนโลยีและนวัตกรรมผลิตภัณฑ์การเกษตร มหาวิทยาลัยศรีนครินทรวิโรฒ (มศว) ส่วนปริญญาโท และ เอก สาขาวิทยาศาสตร์การอาหาร คณะอุตสาหกรรมเกษตร มหาวิทยาลัยเกษตรศาสตร์ค่ะ
ถาม : การที่ศึกษาจบปริญญาตรี-เอกมุ่งเน้นไปที่เรื่องอาหารโดยตรงมีความสนใจอะไรเป็นพิเศษครับ?
ตอบ:
อาจเป็นคนชอบทานและชอบทำอาหาร อีกทั้งสนใจกลไกและกระบวนการที่เกิดขึ้นจนกระทั่งสำเร็จเป็นผลิตภัณฑ์อาหารให้เรารับประทานได้ค่ะ
ถาม : ความสนใจนี้เกิดขึ้นตอนไหนครับ?
ตอบ:
เนื่องจากคุณยายเป็นคนทำอาหารเก่งมาก ตอนเด็กๆ เคยเป็นลูกมือของคุณยาย โดยช่วยหั่นโน่นเตรียมนี่แต่ทำอาหารไม่เป็น จนกระทั่งโตได้มีโอกาสไปทำงานวิจัยต่างประเทศ อยู่เพียงลำพังไม่มีใครทำอาหารให้ทานก็เริ่มทำอาหารเอง ส่วนเบเกอรี่ก็ทำเองบ้างเพราะชอบทาน และบางครั้งรู้สึกว่าร้านที่ไปซื้อรสชาติยังไม่ได้ดังใจ จึงลงมือทำเองค่ะ
ถาม : ตอนเรียนปริญญาเอกที่ต้องศึกษาลงลึก ดร.ก้อยศึกษาอาหารในแง่มุมไหนเป็นพิเศษครับ?
ตอบ:
เริ่มจากสมัยเรียนปริญญาตรี จำได้ว่าเข้าไปบอกอาจารย์ว่าสนใจศึกษาเกี่ยวกับแป้งและต้องการศึกษาต่อ หัวข้อที่ศึกษาในตอนนั้นคือการใช้แป้งมันสำปะหลังทดแทนแป้งสาลีในเค้กเนย
พอเรียนปริญญาโทก็ยังคงศึกษาเรื่องแป้ง แต่เปลี่ยนจากแป้งสาลีและแป้งมันสำปะหลังมาเป็นแป้งข้าวสำหรับทำเส้นจันท์แช่เยือกแข็งและปรับปรุงคุณภาพของเส้นจันท์โดยใช้ไฮโดรคอลลอยด์หรือแป้งดัดแปร
เมื่อเรียนปริญญาเอกก็ศึกษาเกี่ยวกับสตาร์ช (starch) แบบลงลึก แต่เน้นในลักษณะวัสดุศาสตร์คือนำสตาร์ชมันสำปะหลังและสตาร์ชถั่วเขียวมาใช้เป็นแม่แบบ (template) ในการทำให้แคลเซียมคาร์บอเนต (CaCO3) มีรูปร่างเป็นทรงกลม

ที่มา: Sawada, K. 1997. The mechanisms of crystallization and transformation of calcium carbonates. Pure Appl. Chem. 69 (5): 921-928. รูปดัดแปรจาก Sikirić M.D. and Füredi-Milhofer, H. 2006. The influence of surface active molecules on the crystallization of biominerals in solution. Adv. Colloid Interfac. 128-130: 135-158.
โดยปกติผลึกของแคลเซียมคาร์บอเนตมีรูปร่างเป็นเหลี่ยม แต่เราจะใช้โครงสร้างของสตาร์ชที่เราเหนี่ยวนำให้มีประจุลบเพื่อจับ (collect) แคลเซียม เมื่อทำให้แห้งก็จะได้แผ่นฟิล์มที่มีแคลเซียมคาร์บอเนตที่เป็นทรงกลมอยู่ใน สตาร์ชฟิล์ม

รูปผลึกของแคลเซียมคาร์บอเนตในเมทริกซ์ของสตาร์ชฟิล์ม
ถาม : ผลึกของแคลเซียมคาร์บอเนตในสตาร์ชมีความสำคัญอย่างไรครับ?
ตอบ:
เริ่มต้นมีแนวคิดมาจากการทำขนมเปียกปูน ที่เมื่อใส่น้ำปูนใสในแป้งแล้วจะทำให้มีกลิ่นหอมใบเตยมากขึ้น ก้อยศึกษากลไกว่าเกิดอะไรขึ้นในแป้ง ส่วนน้องอีกคนที่เรียนด้วยกันศึกษาการใช้งานเกี่ยวกับกลิ่น ซึ่งพบว่าระบบนี้เก็บกลิ่นได้ดี ตอนนี้ก็ยังเป็นที่สงสัยว่าแคลเซียมคาร์บอเนตช่วยเก็บกลิ่นได้หรือไม่ แต่ก็มีสมมุติฐานว่าอาจมีความเกี่ยวข้องกัน เพราะมีผลเปรียบเทียบระหว่างมีกับไม่มีผลึกแคลเซียมคาร์บอเนต พบว่ากลิ่นที่ปลดปล่อยออกมาไม่เท่ากัน

น้ำปูนใส
ถาม : สรุปแล้วสิ่งที่ค้นพบในการทำงานวิจัยปริญญาเอกคืออะไรครับ?
ตอบ:
สิ่งที่ค้นพบคือการใช้น้ำปูนใสหรือภาวะที่เป็นด่างจะไปดัดแปรโครงสร้างของสตาร์ช โดยตัดสายของสตาร์ชให้สั้นลง และทำให้หมู่ OH เปลี่ยนเป็น O– คือมีประจุที่เป็นลบ ดังนั้นจะสามารถเกิดอันตรกิริยากับแคลเซียมเกิดการเชื่อมขวาง (crosslink) ระหว่างโมเลกุลทำให้โครงสร้างของแป้งที่ใช้ทำขนมเปียกปูนแข็งขึ้น
ถาม : เมื่อมาทำงานที่เอ็มเทคในทีมวัสดุศาสตร์อาหาร งานวิจัยที่เน้นเป็นพิเศษคือด้านไหนครับ?
ตอบ:
ตอนเริ่มเข้ามาในทีมวัสดุศาสตร์อาหาร โจทย์วิจัยหลักที่ทำคือโปรตีนจากพืช เพราะกำลังอยู่ในกระแส แต่ก่อนหน้าที่จะมาทำงานที่เอ็มเทคเคยทำวิจัยหลังปริญญาเอก (postdoctoral position) ที่มหาวิทยาลัยเกษตรศาสตร์มาก่อน งานที่ทำมีความหลากหลายทั้งเรื่องโปรตีน และการย่อย ซึ่งหลังจากนี้ที่ สวทช. จะมีโมเดลจำลองการศึกษากระบวนการย่อยในระบบทางเดินอาหาร (simulated gut model) มาติดตั้ง ดังนั้นงานหลักในอนาคตจะศึกษาเรื่องการย่อยด้วยค่ะ
ถาม : ตอนเรียนในระดับปริญญาโท-เอกเน้นการศึกษาเรื่องแป้งเป็นหลัก แล้วมาเริ่มศึกษาเรื่องโปรตีนในตอนไหนครับ?
ตอบ:
ตอนที่ทำวิจัยหลังปริญญาเอกค่ะ เนื่องจากเป็นโจทย์ใหม่ของกลุ่ม อีกทั้งอาจารย์ที่ปรึกษาก็เป็นผู้เชี่ยวชาญด้านโปรตีน ก้อยจึงได้ความรู้จากอาจารย์ที่ปรึกษาในสมัยนั้นค่ะ
ถาม : หากมองภาพใหญ่ระดับโลก เหตุใดมนุษย์จึงสนใจนำพืชหรือโปรตีนจากพืชมาทำเนื้อสัตว์จำลองครับ?
ตอบ:
น่าจะด้วยความมั่นคงทางอาหารค่ะ เนื่องจากจำนวนประชากรโลกเพิ่มขึ้น การเลี้ยงวัวหรือหมู 1 ตัว ต้องใช้ทรัพยากรธรรมชาติในปริมาณมาก ทั้งพื้นที่ น้ำ อาหารสำหรับเลี้ยงสัตว์ กว่าจะได้เป็นอาหารของมนุษย์
อีกทั้งชาวตะวันตกก็เริ่มสนใจโปรตีนจากพืชมากขึ้น เพราะมีปัญหาเรื่องคอเลสเตอรอลสูง ไขมันในเลือดสูง และภาวะโรคต่างๆ ที่เกิดขึ้น จึงเกิดเป็นกระแส ซึ่งจริงๆ แล้วประเทศในแถบเอเชียรู้จักอาหารเจ หรืออาหารมังสวิรัติมานานแล้ว
ถาม : การที่ชาวตะวันตกรับประทานไขมันมากเพราะอาศัยอยู่ในเขตหนาวเย็น หากเขาหลีกเลี่ยงการทานเนื้อสัตว์มาทานพืชจะสามารถทดแทนกันได้ไหมครับ?
ตอบ:
จริงๆ เป็นการสร้างสมดุลสารอาหารค่ะ ในเนื้อสัตว์มีทั้งไขมันอิ่มตัวและไขมันไม่อิ่มตัว แต่จะมีไขมันอิ่มตัวมากกว่า และมีคอเลสเตอรอล ส่วนในพืชส่วนใหญ่เป็นไขมันไม่อิ่มตัว และไม่มีคอเลสเตอรอล ซึ่งไขมันไม่อิ่มตัวไม่มีผลเสียต่อสุขภาพมากเท่ากับไขมันอิ่มตัวค่ะ
ถาม : นอกจากเรื่องสุขภาพแล้ว การทำปศุสัตว์ที่มักปล่อยแก๊สมีเทน ซึ่งเป็นแก๊สเรือนกระจกที่ถูกปลดปล่อยสู่บรรยากาศโลกมากเช่นกันนั้น เกี่ยวข้องกับกระแสการบริโภคโปรตีนจากพืชแทนเนื้อสัตว์ไหมครับ?
ตอบ:
เกี่ยวข้องกันค่ะ เพราะมีการศึกษาเปรียบเทียบปริมาณโปรตีนที่ผลิตได้ที่เท่ากัน การทำปศุสัตว์จะปล่อยแก๊สเรือนกระจกสูงกว่าการเพาะปลูกพืช
ถาม : เนื่องจากเนื้อสัตว์มีโปรตีน ไขมัน สารอาหาร และแร่ธาตุอื่นๆ การที่เรานำพืชมาทำเนื้อสัตว์จำลอง เราต้องเติมสารทดแทนลงไปเพื่อให้ใกล้เคียงกับเนื้อสัตว์ที่สุดไหมครับ?
ตอบ:
ถ้าเราต้องการให้ใกล้เคียงเนื้อสัตว์ที่สุดก็อาจต้องเติมเข้าไป เพราะพืชไม่มีกรดอะมิโนบางตัวที่เนื้อสัตว์มี แต่สิ่งที่พืชมีคือสารไฟโตสเตอรอล (phytosterol) ซึ่งเป็นสารพฤษศาสตร์เคมี เช่น แกมมาโอไรซานอล ในน้ำมันรำข้าว ที่ทานแล้วช่วยเรื่องลดระดับคอเลสเตอรอลและปรับสมดุลไขมันในร่างกาย
ถาม : การนำโปรตีนจากพืชมาเลียนแบบเนื้อสัตว์มีอุปสรรคหรือความท้าทายทางเทคโนโลยีที่ต้องก้าวข้ามไปให้ได้อะไรบ้างครับ?
ตอบ:
เนื่องจากกระแสความนิยมบริโภคเนื้อสัตว์จากโปรตีนพืชเริ่มมาจากคนที่ทานเนื้อสัตว์ ดังนั้นเขาก็จะยึดติดกับเนื้อสัมผัสในลักษณะเดียวกับเนื้อสัตว์ โปรตีนสัตว์มีลักษณะเป็นเส้นใยยาวเกิดจากการเรียงตัวของแอกทิน (actin) ไมโอซิน (myosin) ซึ่งเป็นส่วนประกอบของไมโอไฟบริล (myofibril)
ในขณะที่โปรตีนพืชเป็นโปรตีนที่สะสมในเมล็ดของพืช เป็นโปรตีนก้อนกลม (globular protein) เป็นสายโพลิเพปไทด์ (polypeptide) ที่ม้วนงอ โครงสร้างไม่ได้เรียงตัวเป็นเส้นตรง ดังนั้น เมื่อทานโปรตีนจากพืชและสัตว์ก็จะให้ความรู้สึกในปากที่แตกต่างกันค่ะ

เนื้อสัตว์ประกอบด้วยไมโอไฟบริลขนาดเล็กมัดรวมกันเป็นมัดกล้ามเนื้อที่มีขนาดใหญ่ขึ้น
ตอนที่เริ่มพัฒนาโปรตีนจากพืช ทานครั้งแรกรู้สึกเหมือนทานถั่วกวนในไส้ขนมเปี๊ยะ แต่เมื่อพัฒนามาเรื่อยๆ จนกระทั่งตอนนี้เวลาเคี้ยวจะให้ความรู้สึกแน่นและมีเส้นใยในปากเหมือนทานเนื้อสัตว์ ได้เคยลองให้หลายๆ คนทั้งภายในและภายนอกองค์กรชิม ต่างก็บอกว่าใกล้เคียงกับเนื้อไก่มาก
เนื่องจากเทคโนโลยีที่เราใช้เป็นการปั่นผสมธรรมดายังไม่ได้ใช้เทคโนโลยีขั้นสูงจึงทำได้เพียงเส้นใยสั้นๆ คล้ายกับนักเก็ต (nugget) หรือเนื้อไก่บด ดังนั้น ทีมวิจัยกำลังศึกษาเทคโนโลยีเอ็กซ์ทรูชัน (extrusion) เพื่อจะทำให้โปรตีนพืชมีลักษณะเส้นใยยาวมากขึ้นใกล้เคียงกับเนื้อไก่ คือเวลาที่ฉีกเนื้ออกไก่จะเห็นเป็นเส้น เทคโนโลยีนี้จะใช้การอัดด้วยความดัน และแรงเฉือน ร่วมกับใช้ความร้อนเพื่อจัดโครงสร้างโมเลกุลให้เป็นเส้นค่ะ
ถาม : การพัฒนาโปรตีนพืชเสมือนเนื้อสัตว์ยังมีแง่มุมไหนที่สามารถพัฒนาต่อได้ไหมครับ?
ตอบ:
ยกตัวอย่างผลิตภัณฑ์ Ve-Chick ซึ่งเป็นผลิตภัณฑ์เนื้อไก่ทำจากโปรตีนถั่วเหลือง เทคโนโลยีที่เราใช้ในการพัฒนาในปัจจุบันยังไม่สามารถทำเป็นเส้นใยยาวได้ อีกทั้งการผลิตเนื้อไก่จากโปรตีนถั่วเหลืองเพื่อส่งออกไปต่างประเทศ ถั่วเหลืองที่ใช้ต้องไม่ตัดต่อสารพันธุกรรม หรือต้องเป็น Non-GMO ซึ่งเราต้องคัดเลือกวัตถุดิบที่มีใบรับรองว่าเป็น Non-GMO เพื่อให้ลูกค้ามั่นใจ
นอกจากนี้ ผู้บริโภคส่วนหนึ่งอาจแพ้โปรตีนถั่วเหลือง ดังนั้น เราต้องเปลี่ยนมาใช้โปรตีนจากพืชชนิดอื่น เช่น ถั่วเขียว ถั่วพีหรือถั่วลันเตา เพื่อหลีกเลี่ยงโปรตีนจากถั่วเหลือง ปัจจุบันเรามี Ve-Chick ในรูปแบบผงสำเร็จรูป (premix) ที่ปราศจากกลูเตน (gluten-free) ซึ่งเป็นสารก่อภูมิแพ้ เพียงแค่ผสมผงสำเร็จรูปนี้กับของเหลวตามสัดส่วนที่กำหนดก็จะได้ผลิตภัณฑ์ทดแทนเนื้อไก่ที่นำไปปรุงอาหารได้ โดยสูตรผงสำเร็จรูปปราศจากกลูเตนนี้มีทั้งสูตรที่ทำจากโปรตีนถั่วลันเตาและถั่วเขียว ซึ่งจะเหมาะสำหรับผู้แพ้ถั่วเหลืองค่ะ
ถาม : ผลิตภัณฑ์ Ve-Chick ต้องได้รับมาตรฐานอุตสาหกรรมอาหาร หรือผ่านเกณฑ์การตรวจสอบจากสำนักงานคณะกรรมการอาหารและยา (อย.) เพื่อรับประกันว่าสามารถรับประทานได้อย่างปลอดภัย หรือส่งออกไปยังกลุ่มลูกค้าที่สนใจบ้างไหมครับ?
ตอบ:
ตอนนี้ Ve-Chick ยังเป็นเพียงต้นแบบห้องปฏิบัติการค่ะ การวิเคราะห์ทดสอบตามมาตรฐานข้างต้นจึงยังไม่ได้ทำ สำหรับเรื่องกฎหมายอาหารในอนาคต อย. อาจมีข้อกำหนดสำหรับผลิตภัณฑ์โปรตีนจากพืชว่าต้องมีอะไรบ้าง แต่ปัจจุบัน (มีนาคม 2564) ยังไม่มีค่ะ แต่แนวโน้มคงต้องมี เพราะบริษัทผู้ผลิตอาหารเริ่มสนใจมากขึ้น เช่น ต้องมีโปรตีนปริมาณเท่าไหร่จึงจะสามารถกล่าวอ้างได้ว่าเป็นเนื้อไก่จากโปรตีนพืช หรือต้องมีสารอาหารในปริมาณเท่าไหร่จึงจะผ่านเกณฑ์มาตรฐาน ซึ่งปัจจุบันใช้กฎหมายอาหารทั่วไปเช่นเดียวกับอาหารมังสวิรัติและอาหารเจ
ถาม : นอกจากสำนักงานคณะกรรมการอาหารและยาแล้ว ยังมีหน่วยงานอื่น หรือเอ็มเทค ส่งตัวแทนเข้าไปมีส่วนร่วมในการพิจารณาข้อกำหนดข้างต้นไหมครับ?
ตอบ:
ณ ปัจจุบัน (มีนาคม 2564) เอ็มเทคยังไม่มีตัวแทนไปเข้าร่วมค่ะ
ถาม : เหตุใดจึงเลือกถั่วเหลืองในการพัฒนาผลิตภัณฑ์ Ve-Chick สามารถใช้วัตถุดิบอื่นแทนได้หรือไม่ครับ?
ตอบ:
เนื่องจากถั่วเหลืองเป็นวัตถุดิบที่หาได้ง่ายในบ้านเรา ต้นทุนไม่สูงมากเมื่อเทียบกับโปรตีนถั่วเขียว ซึ่งประเทศเรายังต้องการการพัฒนาคุณภาพโปรตีนจากถั่วเขียวค่ะ
ถาม : หากมีการพัฒนาต่อยอดไปสู่เชิงพาณิชย์ สามารถคาดการณ์ได้ไหมครับว่า ราคาต่อน้ำหนักของเนื้อสัตว์จากโปรตีนพืชจะไล่เลี่ยหรือสูงกว่าราคาต่อน้ำหนักของเนื้อไก่ครับ?
ตอบ:
คิดว่าต้นทุนการผลิตน่าจะไล่เลี่ยกัน หรืออาจถูกกว่าค่ะ เพราะเท่าที่เคยลองสำรวจราคาของอกไก่จากท้องตลาดเทียบกับราคาของวัตถุดิบที่เราใช้ทำ Ve-Chick ถึงแม้จะเป็นการซื้อในราคาขายปลีกครั้งละไม่เกิน 5 กิโลกรัม ต้นทุนวัตถุดิบของ Ve-Chick ก็ยังมีราคาถูกกว่าค่ะ
ถาม : นอกจากเนื้อไก่แล้ว ทีมวิจัยได้พัฒนาเนื้อสัตว์ประเภทอื่นจากโปรตีนพืชไหมครับ?
ตอบ:
ปัจจุบันยังไม่มีค่ะ แต่มีแผนจะพัฒนาเนื้อกุ้ง หรืออาหารทะเล อาจเป็นเพราะความชอบส่วนตัว ถ้าเราเริ่มจากสิ่งที่ชื่นชอบก็น่าจะสามารถพัฒนาไปได้ไกลค่ะ
เนื่องจากเนื้อสัมผัสของกุ้งมีความยืดหยุ่น (springiness) เมื่อเคี้ยวจะเด้งดึ๋ง สู้ฟัน ดังนั้น การพัฒนาโปรตีนพืชที่เป็นโปรตีนก้อนกลมให้มีเนื้อสัมผัสที่เหมือนกุ้งได้จึงเป็นความท้าทายค่ะ
ถาม : เนื่องจากกุ้งมีหลายประเภททั้งกุ้งทะเล กุ้งแม่น้ำ เนื้อสัมผัสมีความแตกต่างกันไหมครับ และกุ้งที่มีแผนจะพัฒนาต่อไปเป็นกุ้งประเภทไหน?
ตอบ:
แตกต่างกันค่ะ ที่คิดไว้อยากพัฒนากุ้งทะเลเนื่องจากน่าจะมีความท้าทายที่สุด ถ้าเราสามารถทำสิ่งที่ยากที่สุดได้สำเร็จ ก็จะสามารถย้อนกลับมาทำสิ่งที่ง่ายกว่าได้ค่ะ
ถาม : นอกจากเนื้อสัมผัสแล้ว เนื้อกุ้งยังมีสีส้มเป็นลายเส้นอีกด้วย คิดว่าจะทำให้เหมือนได้อย่างไรครับ?
ตอบ:
เรื่องสี ส่วนใหญ่ก็จะใช้สีผสมอาหารที่อาจเป็นสีธรรมชาติหรือสีสังเคราะห์ หรืออาจใช้แครอท ส่วนเนื้อที่เป็นลายเส้นอาจต้องปรับในขั้นตอนการขึ้นรูปด้วยแม่พิมพ์ค่ะ
ในกรณีของเนื้อไก่จากโปรตีนพืช สีจะออกเป็นสีเหลืองขุ่นๆ ก็ต้องปรับที่สูตรให้ได้สีออกขาวโดยที่ไม่ต้องใช้สารเคมี
ถาม : ประเด็นที่กุ้งสุกง่าย การใช้โปรตีนพืชมาทำเนื้อกุ้งจะส่งผลต่อประเด็นดังกล่าวไหมครับ?
ตอบ:
การนำโปรตีนพืชมาโดนความร้อนต่อ กรณีของกุ้งไม่น่าเป็นปัญหา แต่กรณีที่ต้องใช้ความร้อนมากๆ จะมีปัญหา เช่น ถ้าเอาไปต้มนานๆ จะทำให้เนื้อแข็งค่ะ
ถาม : เนื่องจากชาวตะวันตกนิยมบริโภคเนื้อวัว หากต้องการพัฒนาเนื้อวัวจากโปรตีนพืช ประเด็นใดถือเป็นความท้าทายทางวิชาการครับ ?
ตอบ:
การทำให้เนื้อวัวมีสีแดงถือเป็นความท้าทายในขั้นตอนการพัฒนา ซึ่งมักใช้สี และสีที่ใช้จะมี 2 แบบคือ 1) ใช้บีทรูท หรือ 2) สีสังเคราะห์ บางคนสังเคราะห์ฮีม (heme) ซึ่งแบบนี้จะใกล้เคียงกับสีเลือดที่สุด
ถาม : ถ้ามองเชิงพาณิชย์ในระดับโลก ผลิตภัณฑ์ที่ทีมวิจัยพัฒนาขึ้นมีจุดขายที่แตกต่างจากผลิตภัณฑ์ของต่างประเทศอย่างไรครับ?
ตอบ:
จากที่เคยนำเนื้อไก่แบบผงสำเร็จรูปของต่างประเทศมาทดลองใช้ ขั้นตอนการใช้จะต้องนำไปแช่แข็งก่อนเพื่อให้ได้โครงสร้างใกล้เคียงกับเนื้อไก่ แต่ผลิตภัณฑ์ที่เราพัฒนาขึ้นด้วยเทคโนโลยีปั่นผสมสามารถนำไปประกอบอาหาร เช่น ต้ม แกง ทอด ได้เลย


การนำผลิตภัณฑ์ Ve-Chick เนื้อสัตว์จากโปรตีนพืชมาประกอบอาหารเป็นเมนูต่างๆ
นอกจากนี้ ผลิตภัณฑ์ของต่างประเทศบางยี่ห้อจะเติมโปรตีนไข่ลงไปเพื่อช่วยเรื่องเนื้อสัมผัส แต่ผลิตภัณฑ์ของเราผลิตจากพืชล้วนๆ เป็นวีแกน แต่ถ้าจะทานเป็นอาหารเจก็ต้องตัดเครื่องปรุงบางชนิดออก เช่น หอม กระเทียม
ถาม : เนื้อสัตว์จากโปรตีนพืชยังมีมิติอื่นๆ เช่น เรื่องการกำหนดมาตรฐาน หรืองานวิจัยที่คาบเกี่ยวกับเรื่องนี้ที่ทีมวิจัยจะมุ่งเป้าไปในอนาคตไหมครับ?
ตอบ:
ผลิตภัณฑ์ที่เกี่ยวกับโปรตีนพืชที่ทีมพัฒนาคือ M-pro jelly drink ซึ่งเป็นผลิตภัณฑ์เครื่องดื่มเยลลี่โปรตีนสูงเสริมแคลเซียม ซึ่งในอนาคตอาจศึกษาอัตราการย่อยและการดูดซึมของโปรตีนพืชว่าแตกต่างจากโปรตีนสัตว์หรือไม่ เมื่อเราทานโปรตีนพืช สุดท้ายแล้วเราได้โปรตีนมากน้อยแค่ไหน

ผลิตภัณฑ์ M-pro jelly drink ซึ่งเป็นเครื่องดื่มเยลลี่โปรตีนสูงเสริมแคลเซียม
ถาม : ถ้าผู้อ่านสนใจผลิตภัณฑ์เนื้อสัตว์จากโปรตีนพืชสามารถติดต่อผ่านช่องทางไหนครับ?
ตอบ:
ถ้าสนใจรับถ่ายทอดเทคโนโลยีผลิตภัณฑ์ Ve-Chick ที่ทีมวิจัยพัฒนาขึ้น หรือต้องการทำวิจัยร่วมกันเพื่อต่อยอดจากผลิตภัณฑ์ Ve-Chick สามารถติดต่อได้ที่งานประสานธุรกิจและอุตสาหกรรมของเอ็มเทคได้เลยค่ะ
งานประสานธุรกิจและอุตสาหกรรม
โทรศัพท์ : 0 2564 6500ต่อ 4782-4789 โทรสาร 0 2564 6369
E-mail : BDD-IBL@mtec.or.th
คงได้เห็นภาพรวมและรายละเอียดที่น่าสนใจของงานวิจัยเนื้อสัตว์จากโปรตีนพืชว่าก้าวหน้าไปถึงขั้นทำต้นแบบผลิตภัณฑ์อาหารแล้ว เอ็มเทคมีนักวิจัยที่มีความมุ่งมั่นและความชำนาญสูงที่ทำงานร่วมกับนักวิจัยด้านอื่นและบริษัทเอกชน อีกทั้งทิศทางของโลกและโอกาสทางการตลาดน่าจะเติบโตพอสมควร ดังนั้น อนาคตสดใสแน่นอน
ขอขอบคุณ ดร.กมลวรรณ อิศราคาร ที่ให้เกียรติมาร่วมรายการและอัปเดตข้อมูลแก่เรานะครับ
ผู้ที่สนใจรายการนี้ในรูปแบบพอดแคสต์ (podcast) สามารถรับฟังได้ที่
